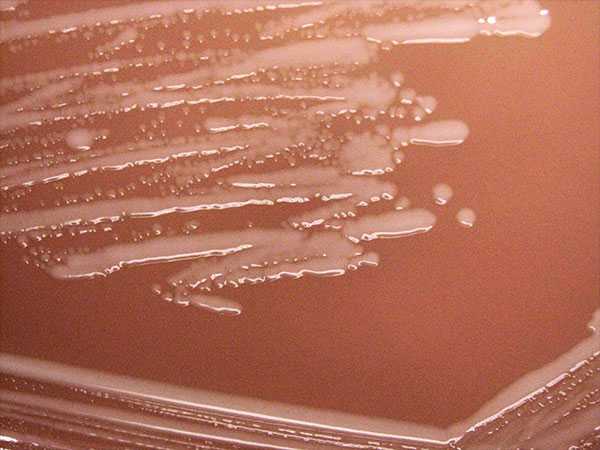
image of H. influenzae (including Hib) is a bacterium that can cause a severe infection, occurring mostly in infants and children younger than five years of age.
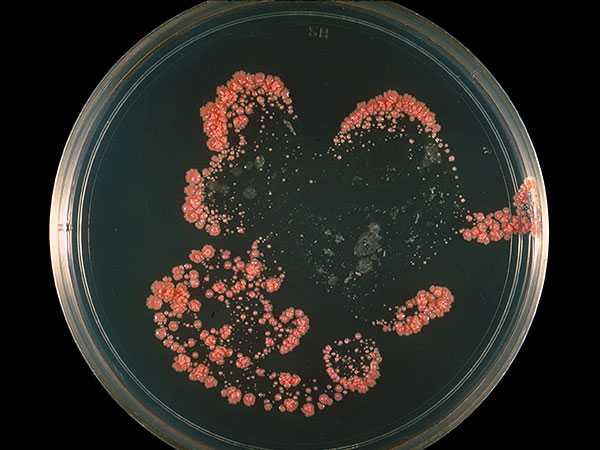
image of culture of bacteria N. asteroides, which causes at least half of invasive infections of nocardiosis

Pathogens and Protocols
MicrobeNet Pathogen Database
As of 2016, the MicrobeNet database contains complete information on more than 2,400 pathogens:
- More than 2,000 bacteria: examples of rare bacteria completely characterized in MicrobeNet are Nocardia, Neisseira, Brevibacterium, Corynebacterium, Gordonia, Klebsiella, and Haemophilus.
- More than 400 fungi, including Histoplasma capsulatum, Blastomyces dermatitidis, and Coccidioides immitis/posadasii, all of which are dangerous organisms causing significant disease and even death in otherwise healthy individuals.
Protocols
Protocols developed and validated by CDC experts are available on MicrobeNet.
- More than 2,000 bacteria including: Esculin, Amino Acid Metabolism, Antibiotic Susceptibility Testing, and Sugar Fermentation.
- Identification of fungi: Sugar Fermentation and Assimilation, Nitrate Assimilation, Urea Hydrolysis, Cycloheximide Susceptibility.
Get Access

To explore the capabilities of this powerful tool, request access to MicrobeNet database.
- Page last reviewed: April 21, 2016
- Page last updated: April 21, 2016
- Content Source:


 ShareCompartir
ShareCompartir